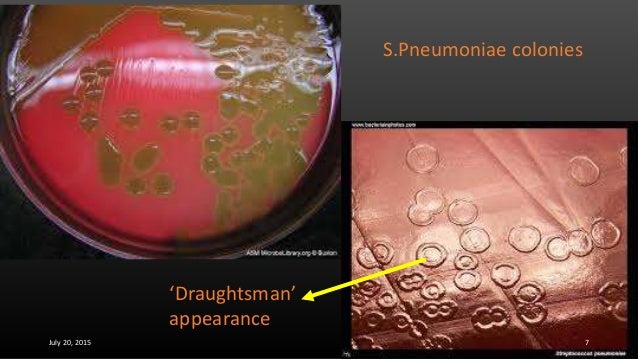

How long does it take to get a strep test?
Your doctor swabs your throat and then tests the sample for the presence of group A Streptococcus bacteria. Rapid strep test results are usually available in 10 to 20 minutes. [4] Your doctor might have you wait in their office to receive your results. If the test is positive, your doctor will typically prescribe antibiotics.
How do you know if a strep test is positive?
- Swelling in the back of the throat
- White spots or white patches on the back of the throat
- Small red or purple spots inside your mouth
Will strep throat go away by itself?
The doctor or medical professional takes a throat swab, called a rapid strep test, or a throat culture. If the test comes back positive for the bacteria, then the doctor will usually prescribe an antibiotic. But strep throat is a self-limited disease that will go away on its own, says Shulman.
How accurate is strep test?
where a rapid strep test is given. This test is about 97% accurate, but sometimes the indicators for strep haven’t shown up yet, Post says. If your test is negative, your health care provider ...
Does a strep test hurt?
If you have a sore throat, a doctor or nurse may wipe the back of your throat to test for strep bacteria. It won't hurt and it only takes a couple of seconds.
How strep test is done?
Your health care provider will use a tongue depressor to hold down your tongue. He or she will use a special swab to take a sample from the back of your throat and tonsils. The sample may be used to do a rapid strep test in the provider's office. Sometimes the sample is sent to a lab.
How long do strep tests take?
Test results are usually available in about 15 minutes. If the rapid strep test indicates a strep infection, the doctor usually will prescribe antibiotics.
What does a strep throat test feel like?
The test can be a little uncomfortable but only lasts a few seconds. You might feel like you have to gag when the doctor swabs your throat -- that's normal. But you'll have to stay still and keep your mouth open so they can get a good sample. If not, they might miss some germs, and you might not get the right medicine.
What does strep smell like?
The mechanism of strep-related bad breath is simple. Tonsils infected with the contagion begin to emit low levels of pus, or dead white blood cells. The decaying cells give off a protein-like odor similar to that exuding from tonsil stones, though generally not as strong.
Can I go to work with strep throat?
People with strep throat should stay home from work, school, or daycare until they no longer have a fever and have taken antibiotics for at least 12 hours. This will help prevent spreading the bacteria to others. Wash your hands often to prevent the spread of germs that cause strep throat and other infections.
Will strep go away on its own?
Strep throat usually goes away on its own within a week with or without antibiotic treatment, but without antibiotics, people may still be contagious for two to three weeks and are at a higher risk for complications.
What happens if u dont treat strep throat?
Pneumonia—when the bacteria that cause strep throat move into the lungs. Toxic shock syndrome—in rare cases, the bacteria can enter the bloodstream. If the bacteria release toxins in multiple organs while in the bloodstream, it causes toxic shock syndrome, which can result in catastrophic organ failure.
How do you know if you have strep throat or just a sore throat?
A viral sore throat is typically accompanied by other cold-like symptoms, such as cough, sneeze, runny nose and a hoarse or raspy voice. “A strep infection can make it feel very painful to swallow, and often comes with fever of 101-degrees or higher,” said Schairer.
When should I get checked for strep throat?
When should I get tested for strep throat? If you have a sore throat that's accompanied by a fever and/or some of the other symptoms described above (especially if these symptoms persist longer than 48 hours), it's a good idea to see a doctor.
How do I not gag during strep test?
You can reduce or eliminate your gag reflex by gradually getting your soft palate accustomed to being touched. One technique is to use a toothbrush on your tongue: Using a soft toothbrush to brush your tongue until you reach the area that makes you feel like you might gag.
Do you gag during strep throat test?
The test for strep throat doesn't hurt, but it might make you gag a little.
Will strep go away on its own?
Strep throat usually goes away on its own within a week with or without antibiotic treatment, but without antibiotics, people may still be contagious for two to three weeks and are at a higher risk for complications.
What happens if u dont treat strep throat?
Pneumonia—when the bacteria that cause strep throat move into the lungs. Toxic shock syndrome—in rare cases, the bacteria can enter the bloodstream. If the bacteria release toxins in multiple organs while in the bloodstream, it causes toxic shock syndrome, which can result in catastrophic organ failure.
How to diagnose strep throat?
Diagnosis. Your doctor will conduct a physical exam, look for signs and symptoms of strep throat, and probably order one or more of the following tests: Rapid antigen test. Your doctor may perform a rapid antigen test on a swab sample from your throat. This test can detect strep bacteria in minutes by looking for substances (antigens) in the throat.
What to do if you have strep throat?
Antibiotics. If your doctor diagnoses you or your child with strep throat, your doctor will likely prescribe an oral antibiotic. If taken within 48 hours of the onset of the illness, antibiotics reduce the duration and severity of symptoms, as well as the risk of complications and the likelihood that infection will spread to others. ...
What is a PCR test?
Molecular (polymerase chain reaction , or PCR) test. This test is also done using a swab sample from your throat. Throat culture. A sterile swab is rubbed over the back of the throat and tonsils to get a sample of the secretions. It's not painful, but it may cause gagging.
What to do if you think your child has strep?
What you can do in the meantime. If you think you or your child might have a strep infection, take steps to relieve symptoms and avoid spreading infection: Keep your hands clean, cover your mouth when you cough or sneeze, and don't share personal items.
What to do when making an appointment for a child's test?
What you can do. When you make the appointment, ask if there's anything you need to do in advance, such as fasting before having a specific test. Make a list of: Symptoms you or your child has, including any that seem unrelated to the reason for your appointment.
Can antibiotics kill strep throat?
In most cases, antibiotics will quickly wipe out the bacteria causing the infection. In the meantime, try these tips to relieve symptoms of strep throat:
What is a strep A test?
Strep A, also known as group A strep, is a type of bacteria that causes strep throat and other infections. Strep throat is an infection that affects the throat and tonsils. The infection is spread from person to person through coughing or sneezing. While you can get strep throat at any age, it's most common in children 5 to 15 years old.
What happens during a strep A test?
A rapid test and a throat culture are done in the same way. During the procedure:
What does it mean if your throat culture is positive?
If the throat culture was positive, it means you or your child has strep throat or other strep infection.
How long does it take to get a strep test?
It provides a more accurate diagnosis than a rapid test, but it can take 24–48 hours to get results. Other names: strep throat test, throat culture, group A streptococcus (GAS) throat culture, rapid strep test, streptococcus pyogenes.
How long does it take for strep throat to go away?
If you or your child was diagnosed with strep throat, you will need to take antibiotics for 10 to 14 days. After a day or two of taking the medicine, you or your child should start to feel better. Most people are no longer contagious after taking antibiotics for 24 hours.
How long does it take for a rapid strep test to show results?
A rapid strep test can provide results in 10–20 minutes. If a rapid test is negative, but your provider thinks you or your child has strep throat, he or she may order a throat culture. Throat culture. This test looks for strep A bacteria.
Where to take a rapid strep sample?
The sample may be used to do a rapid strep test in the provider's office. Sometimes the sample is sent to a lab. Your provider may take a second sample and send it to a lab for a throat culture if necessary.
Purpose of a Group B Strep Test
GBS is usually found in the vagina or rectum, where it can be transmitted to an infant during vaginal delivery.
What to Expect
You don't need to do anything to prepare for this test. They are simple tests to obtain samples that are sent to a lab for analysis. The results are sent back to your provider's office who will communicate them with you.
Results
If the test result is positive, a healthcare provider will give you antibiotics through an IV (intravenous line) during labor, which is more effective than taking antibiotic pills.
Summary
A group B strep test is recommended for pregnant people to help prevent serious infections in newborns. It is a quick and simple test. If you test positive, you'll be given antibiotics as soon as you go into labor. They will be given repeatedly every few hours until delivery, which will kill the bacteria so that it is unlikely to infect your baby.
A Word From Verywell
Group B strep is rare in the United States because most pregnant people have testing to identify the bacteria and get treatment to protect their baby. The test is a simple procedure that can prevent serious illness in your newborn. If you have any concerns about the test, discuss them with your healthcare provider.
What does it mean when a strep is positive?
POSITIVE: Two lines are visible in the control and test zones. It indicates a positive result for Strep A antigen. NEGATIVE: One line is visible in the control zone. It indicates that the concentration of the Strep A antigen is zero or below the detection limit of the test.
How to catch a streptococcus infection?
The most common way to catch the disease is by close contact with an infected person. Specifically, close contact with airborne droplets of an infected individual is the most common way of acquiring Streptococcus infection.
What is a strep throat?
What Is Strep Throat? Strep throat is a bacterial infection of the throat caused by group A streptococcus bacteria. This is a contagious disease that can affect people of all ages, but typically occurs among children and adolescents between the ages of 5 and 15. What are the symptoms of a Strep A infection?
What is the purpose of the N#EZ Level Strep A Test Kit?
Intended Use#N#EZ LEVEL Strep A Test kit is intended for use as an aid in the diagnosis of Group A Streptococcal infection.#N #Test Procedure#N#Mix 4 drops of Reagent 1 and 4 drops of Reagent 2 in the provided tube.
What are the symptoms of strep throat?
The most common symptoms of strep throat are: Fever. Sudden, severe sore throat.
How long to agitate a throat swab?
Swab the throat and agitate the swab inside the tube for 1 minute to mix the specimen with the reagent. Squeeze the swab.
How to prevent strep?
The best way to prevent the spread of strep is to wash your hands frequently with soap and warm water, especially after coughing and sneezing and before preparing foods or eating. Also, if you or a family member is sick, that person should be seen by a doctor and stay home from work, school, or child care.
Where is group B strep test performed?
Group B strep tests are quick, easy, and painless. The procedure is usually performed in your health care provider’s office, although they may give you the option to collect the samples yourself at home.
What is a strep B test?
The strep B test is used to determine whether pregnant women carry the common bacteria known as streptococcal bacteria. This bacteria, found in approximately two in five people, is usually harmless. For pregnant women, however, strep B can lead to complications. That’s why health care providers usually recommend that pregnant women take group B strep tests as a precaution.
What is the condition of a baby with a B streptococcus?
Group B streptococcus can cause inflammation and infection in the mother and baby. This condition is often referred to as GBS disease . For the mother, this can lead to several health problems throughout the pregnancy, including sepsis, bacteremia, pneumonia, and urinary tract infection. If you have a C-section, the presence of group B strep can lead to an infection in the wound after delivery. It can also increase the risk for infection of the amniotic fluid and placenta (chorioamnionitis) and infection of the uterine membrane lining (endometritis).
What group of strep test is used during pregnancy?
Group B Strep Test During Pregnancy: What to Expect
How many babies develop strep?
Approximately 900 babies born in the United States develop the early-onset disease per year, and approximately 1,200 babies develop the late-onset disease. Undergoing the group B strep test at the right time in your pregnancy can help protect you and your baby before, during, and after labor.
When to take group B strep test?
To identify group B strep, many pregnant women take the group B strep test during the third trimester of their pregnancy. This helps prevent health complications that might arise during or after the birth.
When does strep B show up in a baby?
These health issues can show up just after the baby is born or months afterward. Babies who are exposed to strep B usually develop one of the two types of GBS disease. Early-onset GBS develops within the first week of the baby’s life, and the late-onset variety develops within the first three months.
Diagnosis
- Your doctor will conduct a physical exam, look for signs and symptoms of strep throat, and probably order one or more of the following tests: 1. Rapid antigen test.Your doctor may perform a rapid antigen test on a swab sample from your throat. This test can detect strep bacteria in minutes by looking for substances (antigens) in the throat. If the ...
Treatment
- Medications are available to cure strep throat, relieve its symptoms, and prevent its complications and spread.
Lifestyle and Home Remedies
- In most cases, antibiotics will quickly wipe out the bacteria causing the infection. In the meantime, try these tips to relieve symptoms of strep throat: 1. Get plenty of rest.Sleep helps your body fight infection. If you have strep throat, stay home from work if you can. If your child is ill, keep him or her at home until there's no sign of fever, and he or she feels better and has taken an antibiotic f…
Preparing For Your Appointment
- What you can do
When you make the appointment, ask if there's anything you need to do in advance, such as fasting before having a specific test. Make a list of: 1. Symptoms you or your child has, including any that seem unrelated to the reason for your appointment 2. Key personal information, includi… - What to expect from your doctor
Your doctor is likely to ask a number of questions, including: 1. When did the symptoms begin? 2. Have the symptoms changed over time? 3. How severe are the symptoms? 4. Have you or your child been exposed to anyone with strep throat in the last couple of weeks? 5. Does anything se…